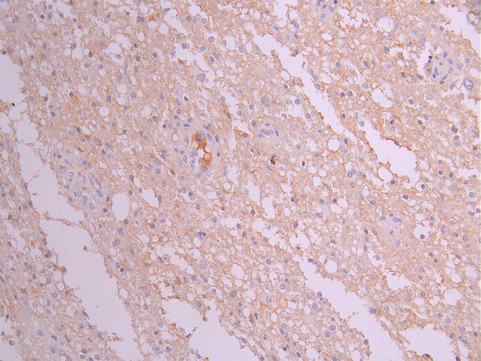

DCX Recombinant Monoclonal Antibody
-
中文名稱:DCX Recombinant Monoclonal Antibody
-
貨號(hào):CSB-RA006576MA1HU
-
規(guī)格:¥1320
-
圖片:
-
IHC image of CSB-RA006576MA1HU diluted at 1:50 and staining in paraffin-embedded human testis tissue performed on a Leica BondTM system. After dewaxing and hydration, antigen retrieval was mediated by high pressure in a citrate buffer (pH 6.0). Section was blocked with 10% normal goat serum 30min at RT. Then primary antibody (1% BSA) was incubated at 4°C overnight. The primary is detected by a Anti-Human lgG, Fcy Fragment Specific labeled by HRP and visualized using 0.05% DAB.
-
IHC image of CSB-RA006576MA1HU diluted at 1:50 and staining in paraffin-embedded human brain tissue performed on a Leica BondTM system. After dewaxing and hydration, antigen retrieval was mediated by high pressure in a citrate buffer (pH 6.0). Section was blocked with 10% normal goat serum 30min at RT. Then primary antibody (1% BSA) was incubated at 4°C overnight. The primary is detected by a Anti-Human lgG, Fcy Fragment Specific labeled by HRP and visualized using 0.05% DAB.
-
IHC image of CSB-RA006576MA1HU diluted at 1:50 and staining in paraffin-embedded human glioma cancer performed on a Leica BondTM system. After dewaxing and hydration, antigen retrieval was mediated by high pressure in a citrate buffer (pH 6.0). Section was blocked with 10% normal goat serum 30min at RT. Then primary antibody (1% BSA) was incubated at 4°C overnight. The primary is detected by a Anti-Human lgG, Fcy Fragment Specific labeled by HRP and visualized using 0.05% DAB.
-
-
其他:
產(chǎn)品詳情
-
Uniprot No.:
-
基因名:DCX
-
別名:DBCN antibody; Dbct antibody; DC antibody; DCX antibody; DCX_HUMAN antibody; Doublecortex antibody; Doublin antibody; FLJ51296 antibody; Lis X antibody; Lis-X antibody; Lissencephalin X antibody; Lissencephalin-X antibody; Lissencephaly X linked antibody; Lissencephaly X linked doublecortin antibody; LISX antibody; Neuronal migration protein doublecortin antibody; OTTHUMP00000023859 antibody; OTTHUMP00000023860 antibody; OTTHUMP00000216315 antibody; OTTHUMP00000216316 antibody; SCLH antibody; XLIS antibody
-
反應(yīng)種屬:Human
-
免疫原:Recombinant Human DCX protein
-
免疫原種屬:Homo sapiens (Human)
-
標(biāo)記方式:Non-conjugated
-
克隆類型:Monoclonal
-
抗體亞型:hIgG1
-
純化方式:Affinity-chromatography
-
克隆號(hào):5E12
-
濃度:It differs from different batches. Please contact us to confirm it.
-
保存緩沖液:Preservative: 0.03% Proclin 300
Constituents: 50% Glycerol, 0.01M PBS, PH 7.4 -
產(chǎn)品提供形式:Liquid
-
應(yīng)用范圍:ELISA, IHC
-
推薦稀釋比:
Application Recommended Dilution IHC 1:50-1:200 -
Protocols:
-
儲(chǔ)存條件:Upon receipt, store at -20°C or -80°C. Avoid repeated freeze.
-
貨期:Basically, we can dispatch the products out in 1-3 working days after receiving your orders. Delivery time maybe differs from different purchasing way or location, please kindly consult your local distributors for specific delivery time.
-
用途:For Research Use Only. Not for use in diagnostic or therapeutic procedures.
相關(guān)產(chǎn)品
靶點(diǎn)詳情
-
功能:Microtubule-associated protein required for initial steps of neuronal dispersion and cortex lamination during cerebral cortex development. May act by competing with the putative neuronal protein kinase DCLK1 in binding to a target protein. May in that way participate in a signaling pathway that is crucial for neuronal interaction before and during migration, possibly as part of a calcium ion-dependent signal transduction pathway. May be part with PAFAH1B1/LIS-1 of overlapping, but distinct, signaling pathways that promote neuronal migration.
-
基因功能參考文獻(xiàn):
- Age-associated expression of the proliferation and immature neuron markers MKI67 and DCX, respectively, was unrelated, suggesting that neurogenesis-associated processes are independently altered at these points in the development from stem cell to neuron. PMID: 28766905
- specifically recognizes compacted GDP-like microtubule lattice PMID: 27238282
- this suggests that the microtubule-interacting doublecortin domain observed in cryo-electron micrographs is the C-terminal domain rather than the N-terminal one. PMID: 27226599
- From this family, we conclude that a DCX mutation causes a pleiotropic phenotype in the female even if X chromosome inactivation pattern is not skewed, and the novel missense mutation in DCX produced relatively mild dysfunction of the doublecortin protein. PMID: 25868952
- We identified a novel DCX mutation c.785A > G, p.Asp262Gly in a family with X-linked lissencephaly and subcortical band heterotopia PMID: 27292316
- In high-risk metastatic Neuroblastoma, TH and DCX mRNA quantification could be used for the assessment of response to treatment and for early detection of progressive disease or relapses. PMID: 26498952
- Results point to a critical role of doublecortin in the formation of the neuromuscular junctions. PMID: 25817838
- It was conclude that microtubule ends have two distinct features that proteins can recognize independently, namely a structural feature related to curvature and nucleotide state. PMID: 25283777
- DCX-positive cells occur in a wide range of hypothalamic nuclei in humans, mice and sheep. PMID: 24288185
- human DCX protein was expressed in human adipose stem cells, collagen II was decreased while aggrecan, matrilin 2, and GDF5 were increased during the 14-day pellet culture. PMID: 24758934
- We propose that DCDC2 is a tumor suppressor gene of HCC. PMID: 24034596
- in utero doublecortin knockdown, but not knockout, shows a neocortical neuronal migration phenotype. PMID: 24945770
- Immunoblots revealed that depressed subjects displayed increased expression of doublecortin. PMID: 23260340
- coexpression of DCX and SPARC collaboratively diminished radioresistance of glioma cells. PMID: 23846421
- DCX is dispensable for the development of new neurons in adult mice PMID: 23667508
- one deleterious mutation in the DCX gene was identified in a 5-year-old girl with lissencephaly spectrum PMID: 23583063
- This finding points to the possible implication of mosaic deletions in the DCX gene in unexplained forms of subcortical band heterotopia (SBH) and may allow for detection of SBH prenatally. PMID: 22833188
- DCX binds to polymerization intermediates at growing microtubule ends, in support of a mechanism for stabilizing 13-protofilament microtubules. PMID: 22727374
- Data report a negative correlation between DCX mRNA expression and white matter neuron density in schizophrenia, in contrast to a positive correlation in human development where DCX mRNA and white matter neuron density are higher earlier in life. PMID: 21966452
- Up-regulation of doublecortin is associated with brain damage in children with acute lymphoblastic leukemia PMID: 21846577
- DCX synthesis induces apoptosis in brain tumor stem cells (BTSC) through a novel JNK1/neurabin II/DCX/PP1/caspase-3 pathway. PMID: 21477071
- study describes male siblings with Lennox-Gastaut syndrome and pachygyria with a novel missense mutation in the DCX gene PMID: 20726879
- The DCX binding on the microtubules surface indirectly stabilizes conserved tubulin-tubulin lateral contacts in the microtubules lumen, operating independently of the nucleotide bound to tubulin. PMID: 20974813
- variants in doublecortin- and calmodulin kinase like 1, a gene up-regulated by BDNF, have roles in memory and general cognitive abilities PMID: 19844571
- Evidence for a role for miR-128 in neuroblastoma progression and aggressiveness through reelin and DCX expression is reported. PMID: 19713529
- During development of the cerebral cortex DCX is expressed in both pyramidal and non-pyramidal migrating cells, as well as in Cajal-Retzius cells. PMID: 12427674
- Missense DCX mutations may manifest as non-syndromic mental retardation with cryptogenic epilepsy in female subjects and subcortical band heterotopia (SBH) in boys. PMID: 12838518
- Different clinical and morphological phenotypes in monozygotic twins with identical DCX mutation. PMID: 14999500
- both mutant and wild type DCX are able to bind and bundle microtubules; however, mutants possess a decreased ability to perturb the mitotic machinery, to cause abnormal spindle orientation, and to impair mitotic progression PMID: 15045646
- DCX maps at Xq22.3 and is caused by a homozygous mutation. It acts during corticogenesis on radial migratory pathways. PMID: 15057976
- We analysed the human DCX regulatory sequence and confined it to a 3.5-kb fragment upstream of the ATG start codon. This fragment is sufficient and specific to drive expression of reporter genes in embryonic and adult neuronal precursors PMID: 15663475
- doublecortin (DCX) gene as a new molecular marker of neuroblastoma cells PMID: 15714065
- Collectively, the immunohistochemistry, Western blots and Northern blots conclusively demonstrate expression of DCX by human brain tumors. PMID: 16195916
- Doublecortin can be regarded as specific neuronal marker only in normal developing brain, but lacks specificity in glioneuronal and glial tumours and other non-neuronal human tissues where it is expressed in a wide variety of tumours and tissues. PMID: 16520969
- X-ray structure of a mutant of N-DCX, in which the C-terminal fragment (residues 139-147) unexpectedly shows an altered, "open" conformation PMID: 16835924
- Our data in the mouse, identifying roles for Dcx in hippocampal and corpus callosal development, might suggest intrinsic roles for human DCX in the development of these structures. PMID: 17111359
- Doublecortin (DCX) is one of the three genes found from Affymetrix gene chip analysis related to glioma patient survival. PMID: 17178868
- MLPA uncovers large genomic deletions of the DCX gene in a subset of patients with SBH in whom no mutations are found after gene sequencing. Deletions of DCX are an underascertained cause of SBH. PMID: 17283321
- Results demonstrate that DCX can be used as a marker to distinguish articular chondrocytes from other chondrocytes and to evaluate the quality of tissue engineered or regenerated cartilage in terms of their "articular" or "non-articular" nature. PMID: 17897623
- Doublecortin is applicable for the detection of individual infiltrating glioma cells when combined with other markers. PMID: 18415660
- X-linked lissencephaly patients with mutations in the C-DC domain tended to have a less severe lissencephaly (grade 4-5 in 58.3%) compared with those in the N-DC domain (grade 4-5 in 36.3%. PMID: 18685874
- intragenic deletions and duplications of the DCX gene account for a significant number of patients with isolated lissencephaly sequence and subcortical band heterotopia, where no molecular defect had previously been identified. PMID: 19050731
- Doublecortin (DCX) upregulation, correlates with better neurologic outcome in children following traumatic head injury. PMID: 19221293
顯示更多
收起更多
-
相關(guān)疾病:Lissencephaly, X-linked 1 (LISX1); Subcortical band heterotopia X-linked (SBHX)
-
亞細(xì)胞定位:Cytoplasm. Cell projection, neuron projection.
-
組織特異性:Highly expressed in neuronal cells of fetal brain (in the majority of cells of the cortical plate, intermediate zone and ventricular zone), but not expressed in other fetal tissues. In the adult, highly expressed in the brain frontal lobe, but very low ex
-
數(shù)據(jù)庫(kù)鏈接:
Most popular with customers
-
-
YWHAB Recombinant Monoclonal Antibody
Applications: ELISA, WB, IHC, IF, FC
Species Reactivity: Human, Mouse, Rat
-
Phospho-YAP1 (S127) Recombinant Monoclonal Antibody
Applications: ELISA, WB, IHC
Species Reactivity: Human
-
-
-
-
-